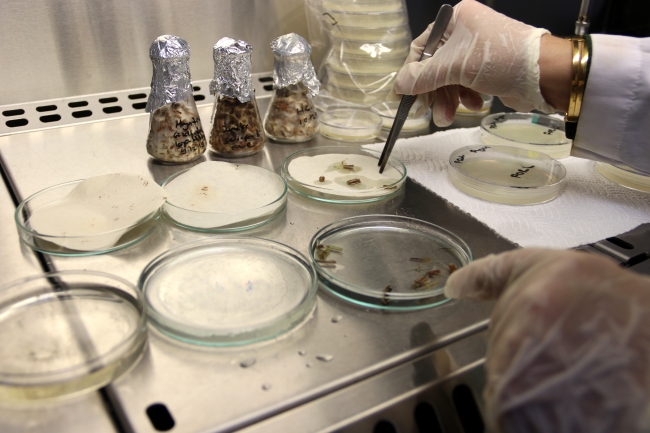
Yerli domatesler verim için zorlu testlerden geçiriliyor

Bölgede yetiştirilen birçok bitki çeşidi üzerinde çalışmalar yürüten GAPTAEM mühendisleri, Milli Tarım Projesi kapsamında yerli ve milli çeşitleri geliştirmek için büyük çaba sarf ediyor.
Bölgede yetiştirilen 20 domatesin genotipini toplayan mühendisler, bu çeşitleri tarla ve laboratuvar ortamında sıcaklık, tuzluluk ve hastalık testlerinden geçiriyor.
Bu zorlu testler sonrasında ıslah edilerek verimi, kalitesi ve dayanıklılığı arttırılacak yeni domates çeşitleri üreticilerin kullanımına sunulacak.

"Laboratuvar ortamında bitkilere hastalık vererek test ediyoruz"
GAPTAEM Müdürü İbrahim Hail Çetiner, AA muhabirine yaptığı açıklamada, bölgenin hava koşullarının ve hastalıkların sebze bitkilerinin üzerinde etkili olduğunu söyledi.
Üreticilere kaliteli ve verimli domates çeşitleri sunmak amacıyla çalışmalar yürüttüklerini anlatan Çetiner, Kilis, Adana, Mardin ve Şanlıurfa'da üreticilerin tercih ettiği yerli domates çeşitlerinden 20 tanesini toplayarak bazı testlere tabi tuttuklarını ifade etti.
Çetiner, bitkilerin önce tarlada sıcaklık ve tuzluluğa karşı dayanıklılığını ölçtüklerini belirterek, şöyle dedi:
"Kurak ve tuzluluk testinden geçen, dayanıklı çıkan yerel çeşitlerimizden hangilerinin hastalığa da dayanıklı olduğunu belirlemek için bunları da laboratuvar ortamında bitkilere hastalık vererek test ediyoruz. Burada yine yerli tohumların yanında ticari amaçlı kullanılan iki domates çeşidini de yerli çeşitlerimizle birlikte hastalığa karşı yarıştırıyoruz. Amacımız hastalıklara, zararlılara, sıcaklığa ve tuzluluğa karşı dayanıklı yerli domates çeşitlerinden yeni çeşitler elde edip, tescil ederek çiftçilerimizin hizmetine, tarıma ve ülke ekonomisine katkı sunmak."

"Hastalıklara dayanıksız olanlar kuruyor"
Bitki Sağlığı Bölümü Fitopatoloji Birimi Sorumlusu Sebze Hastalıkları Uzmanı Dr. Ayşin Bilgili de domates çeşitlerinde en fazla mantar hastalıklarından kaynaklı kök ve kök boğazı çürüklüğünün oluştuğunu ifade etti.
Tarladaki bitkilere bulaşan hastalıkları laboratuvar ortamında izole ettiklerini ve bu hastalıkları domates çeşitleri üzerinde teste tabi tuttuklarını aktaran Bilgili, bu testler sayesinde bitkinin dayanıklılığını belirlediklerini söyledi.
Bilgili, yapılan testler sonunda hastalıklara dayanıksız olan bitkinin kuruduğunu belirterek, "Bütün bu hastalıklara, sıcaklığa ve tuzluluğa direnç gösteren verimi yüksek olan yerli çeşitleri ıslah çalışmasının ardından tescile gönderiyoruz" dedi.